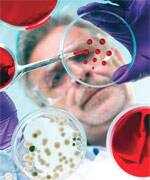
Systemic Anti-Aging Protection

Life Extension Magazine®

Since the year 2001, Life Extension® has been seeking a way to reverse a mechanism of aging that may not be adequately addressed by the healthy lifestyle choices most members currently follow.
Normal aging is accompanied by a noticeable increase in fatigue and loss of motivation. The tiredness we outwardly feel reflects inward impairment of cellular functions critical to sustaining life.
NAD+ is the term used in the scientific literature to describe a cellular compound called nicotinamide adenine dinucleotide.
NAD+ is found in every cell in the body and is essential to life.1,2 NAD+ enables the transfer of energy from the foods we eat to vital cell functions. It is also required to “turn off” genes that accelerate degenerative aging processes.3,4
As NAD+ levels decline, mitochondrial function is impaired, resulting in fewer mitochondria surviving.3,5 This vicious cycle of mitochondrial depletion results in many of the physical symptoms of aging.
The challenge we at Life Extension have faced over the past 13 years is finding an efficient way for aging humans to affordably boost their NAD+ cellular levels.
In 2001, one of our researchers developed an effective NAD+ boosting sublingual lozenge, but it only maintained stability for a short time period. As you’ll read in this article, an effective NAD+ cell boosting technology has finally become available.
Prominent universities have been investigating NAD+ as a potential therapy for age-related degenerative disease.6 Compelling research shows that NAD+ has a unique ability to protect tissues, induce DNA repair, and increase life span.2,7,8
It has long been known that NAD+ plays an important role in transferring energy released from glucose and fatty acids to the mitochondria so that it can be converted into cellular energy.2,9 Without sufficient NAD+, energy transfer in the cells breaks down, resulting in age-accelerating mitochondrial dysfunction.5,10,11
NAD+ is an essential cofactor of key enzymes responsible for longevity called sirtuins.5,12,13 While resveratrol is well known for sirtuin activation, evidence indicates it does so indirectly,14,15 whereas NAD+ directly activates sirtuins to regulate the genes of aging.2,16
Sirtuins, specifically SIRT1 and SIRT3, are intimately related to longevity through their control of gene expression and require NAD+ for their activity.2,3,10,17-19
Research into the sirtuins continues to yield substantial information on how to control aging. By activating these sirtuins, we’re able to gain control over one of our body’s anti-aging “switches.” SIRT enzymes “turn off” certain genes that promote aging, such as those involved in inflammation,20,21 in fat synthesis and storage,22,23 and in blood sugar management.3,22,23
SIRT enzymes are activated by calorie restriction, the proven means of reliably extending life span in all organisms.2,24 The way calorie restriction activates anti-aging sirtuins is by increasing cellular NAD+.2,25,26
Consequences Of Falling NAD+ Levels
NAD+ is found in every single cell in the body,1 and is essential for efficient energy transfer from foods to tissues. NAD+ is also required for turning off genes that accelerate aging.4
From a cellular energy standpoint, lower levels of NAD+ reduce mitochondrial function, with fewer energy-rich ATP molecules being produced, and fewer mitochondria produced.5,11 This vicious cycle results in many of the physical symptoms of aging.
The age-related decrease in NAD+ causes defects in both energy- and gene-related functions to accumulate. These defects feed on one another to produce the disorders we typically identify as aging.10 The consequences of a decline in NAD+ levels and subsequent reduction in SIRT 1 and SIRT 3 enzymes are:
- Neurodegeneration in the brain,10,27,28
- Vascular inflammation, producing damage to blood vessels that can result in stroke or heart attack, 27,29,30
- Increased fat storage in the liver, which can lead to nonalcoholic fatty liver disease (NAFLD),31-33
- Increased fat production and deposition in white adipose tissue, the primary fat storage form found in dangerous belly fat,34,35
- Insulin resistance, preventing cells from appropriately removing glucose from blood, producing higher blood sugar levels and leading directly to metabolic syndrome,30,36,37
- Fatigue, loss of muscle strength, and fatty infiltration of muscles, resulting in reduced fatty acid oxidation (“burning”), thereby depriving muscles of their normal sources of energy.38,39
To avoid these degenerative processes, it is essential that steps be taken to optimize the amount of NAD+ in our bodies.
By increasing intracellular NAD+ levels, age-related mitochondrial dysfunction can be reversed.5 One of the ways to accomplish this is by engaging in major calorie restriction, which has been proven to raise NAD+ levels and in experimental organisms tested to date, to extend life span.5,25 But most people find significant calorie restriction to be nearly impossible in practice.
Fortunately, a method has been developed to increase NAD+ levels without having to alter dietary patterns, though Life Extension remains a strong advocate of calorie restriction for those able to consistently do it.
A Natural NAD+ Booster
Researchers have discovered a form of vitamin B3 that converts in the body to NAD+.40,41
Vitamin B3 is involved in over 400 enzymatic reactions throughout the body and is essential for production and management of cellular energy.42 A new patented form of this vitamin called nicotinamide riboside has been found to increase NAD+ levels and in the process, provide an extraordinary range of longevity benefits that promises to change how we combat aging.
Directly boosting NAD+ with nicotinamide riboside presents a new and effective strategy for preventing the natural decline in cellular energy as we age by promoting youthful vitality.
Studies have shown that nicotinamide riboside switches “off” the genes of aging, extends life span, increases endurance, improves cognitive function, activates sirtuins, and enhances cellular energy.3,43 These benefits add up to a system-wide slowing and reversal of certain aging processes. Nicotinamide riboside accomplishes this NAD+ boosting effect without the irritating skin flushing and rash caused by the standard forms of vitamin B3.41
What You Need To Know
![]() |
Systemic Anti-Aging Protection
- A major advance in “systemic anti-aging medicine” is now available for supplementation in humans.
- Nicotinamide riboside is a “next-generation” form of vitamin B3 that supports the vitamin’s functions throughout the body by boosting levels of a key metabolic cofactor called NAD+.
- NAD+ is found in every single cell in the body, and is an absolute requirement for normal, efficient, and safe energy transfer from food to tissues.
- New discoveries show that NAD+ is also essential for silencing genes for proteins that accelerate aging, such as those involved in inflammation, in fat synthesis and storage, and in blood sugar management.
- Supporting NAD+ levels with nicotinamide riboside supplementation extends life span in laboratory organisms, while boosting energy, physical performance, and cognition in aging animals.
- To fight aging throughout your body by restoring youthful function of basic life-sustaining processes in every single cell, begin regular supplementation today with nicotinamide riboside.
Initial Studies On Nicotinamide Riboside
In their investigations into the effects of nicotinamide riboside on life span, scientists used a strain of yeast known to have a relatively short average life span of about 8.3 generations.3,44 When the yeast was treated with nicotinamide riboside, the average life span nearly doubled, to 16.1 generations. On this model of life span extension, ordinary vitamin B3 had no effect compared to the dramatic longevity benefit shown with nicotinamide riboside.3
Nicotinamide riboside is a dynamic compound that works through multiple mechanisms to promote life extension. Most dramatic are its effects on longevity and metabolism, as shown by recent laboratory studies.
One critical mechanism in oxygen-consuming organisms is mitochondrial function.45 Mitochondria, the tiny, intracellular “furnaces” that power cellular processes, are sites of intense electrical and chemical activity.46,47 They can readily “burn out,” contributing to the aging of tissues, and hence, of organs and entire organisms.
In a model commonly used to study life span modifications, the roundworm C. elegans could be made to survive as much as 16% longer when supplemented with nicotinamide riboside. This life span extension was demonstrated to result from a roughly 50% increase in healthy mitochondrial oxygen consumption, a measure of mitochondrial efficiency.48
These benefits are what one would predict from nicotinamide riboside supplementation, which raises levels of the NAD+ needed to safely move electrons through the mitochondria.43 We have long known that ineffective mitochondrial electron transport is an age-accelerating process.43,49,50
When pursuing additional lab studies, scientists found that supplementing mice with nicotinamide riboside reduced many dangerous factors of aging. The mice showed increased energy and improved insulin sensitivity, both factors indicating optimal vitality. In this study, scientists also demonstrated that nicotinamide riboside supplementation increased energy metabolism while protecting the animals against the metabolic abnormalities induced by a high-fat diet.43 For the study, the mice were fed a high-fat diet with either no supplementation (control), or nicotinamide riboside for 12 or 16 weeks.
On a treadmill test, the supplemented animals fed a high-fat diet ran more than 33% further than the control mice, demonstrating a dramatic increase in muscle endurance and performance.43
The supplemented mice also gained significantly less weight while on the high-fat diet compared to control animals. And in supplemented animals fed either the high-fat or a normal diet, insulin sensitivity (the ability to remove sugar efficiently from the blood) was greatly improved, compared with control animals.
Remarkably, these results were all attained without any differences in food intake or total physical activity between supplemented and control mice.43 The supplemented animals lost weight, performed better at exercise, and managed their blood glucose better purely as a result of nicotinamide riboside-induced increases in calorie-burning (measured by increased oxygen consumption rates). This was confirmed by the observation that when the supplemented mice were exposed to prolonged cold conditions, they had significantly less body temperature loss compared to controls, the result of increased conversion of calories to heat.
Detailed analysis of the mice in this study revealed that supplementation with nicotinamide riboside had produced a significant increase in essential NAD+ levels, resulting in the activation of the critical life span-extending enzymes SIRT1 and SIRT3.43 Supplementation with nicotinamide riboside also improved the numbers and function of mitochondria, the intracellular powerhouses that release energy from food; poor mitochondrial function is a known age-accelerator.
Nicotinamide Riboside Protects Brain Cells
As cases of dementia and Alzheimer’s reach epidemic proportions in the aging population, pharmaceutical companies are aggressively researching brain protective compounds.51,52 Nicotinamide riboside with its ability to directly increase NAD+ is providing promising brain benefits.
A recent lab study demonstrated the ability of nicotinamide riboside to protect brain cells in advanced age.9 For the study, mice engineered to develop Alzheimer’s disease were treated with nicotinamide riboside beginning at middle age (5 to 6 months) and lasting into old age (10 to 11 months).
The supplemented animals had significant improvements in their cognitive function in challenging laboratory tests of exploring new objects.9 This improvement was shown to be associated with significantly reduced brain levels of beta-amyloid plaques, the abnormal protein that triggers much of the neuronal death and dysfunction in Alzheimer’s disease. Intriguingly, supplementation had the added benefit of raising levels of the metabolic regulatory complex called PGC-1-alpha. Studies have shown that low levels of PGC-1-alpha have been associated with increased dangerous beta-amyloid deposition.9
The mechanisms by which these effects were achieved were found to include significant increases in brain levels of NAD+ (the result of supplementation with nicotinamide riboside), and consequently activated enzymes involved in cellular energy production and energy release from glucose.9
In a similar study of neuroprotection, nicotinamide riboside was shown to delay the degeneration of axons, the “communication cables” of nerve cells that carry impulses over long distances.53,54 When these communication cables deteriorate, tingling, weakness, numbness, and loss of motor function can occur as a result.55-57 The mechanism behind this benefit was shown to be a significant 20-fold increase in the enzyme that converts nicotinamide riboside to NAD+.54
Other studies in mammalian cells in culture demonstrate that nicotinamide riboside treatment increases NAD+ concentrations inside of cells by up to 2.7-fold,58 and that administering nicotinamide riboside can improve NAD+ related deficiencies in animal and yeast cells.24
![]() |
“Restoring NAD+ by supplementing NAD+ intermediates can dramatically ameliorate these age-associated functional defects, counteracting many diseases of aging, including neurodegenerative diseases. Thus, the combination of sirtuin activation and NAD+ intermediate supplementation may be an effective anti-aging intervention, providing hope to aging societies worldwide.” 10
Summary
Researchers have discovered and patented a no-flush form of vitamin B3 that is revolutionizing the field of aging research.
Unlike earlier forms of this vitamin, nicotinamide riboside has been found to provide an extraordinary range of impressive longevity benefits that promise to change how science approaches the reduction of aging.
Studies have shown that nicotinamide riboside switches “off” the genes of aging, extends life span, increases endurance, improves cognitive function, activates sirtuins, and enhances cellular energy.
As we age, and our NAD+ levels dramatically decline, we begin to experience fatigue and are more susceptible to neurodegeneration and cellular dysfunction. What makes the nicotinamide riboside form of vitamin B3 so unique is that once it is processed by the body it immediately converts into the powerful molecule NAD+.
Nicotinamide riboside accomplishes this NAD+ boosting effect without the irritating skin flushing and rash caused by the standard forms of vitamin B3.
If you feel increasingly lethargic or unmotivated as you age, you can probably blame your falling NAD+ levels, which result in reduced cellular energy production.
Directly boosting NAD+ with nicotinamide riboside presents a new and effective strategy for preventing the natural decline in cellular energy as we age by promoting youthful vitality.
If you have any questions on the scientific content of this article, please call a Life Extension® Health Advisor at 1-866-864-3027.
How NAD+ Drives Longevity-Promoting SIRT Enzymes
![]() |
SIRT enzymes regulate how genes are expressed from the DNA on our chromosomes in part by influencing chromosomal proteins called histones.59,60 Research indicates SIRT enzymes have a “slot” capable of binding to one NAD+ molecule and one chemical acetyl (AC) group from the histone. 61 This binding triggers the SIRT enzyme to remove the acetyl group and bind the histone proteins more closely to their DNA strands, thereby regulating the expression of genes.4,17,31,62 This is shown schematically below.
So, just as a coin in a parking meter slot adds time to the meter with each turn of the handle, a NAD+ molecule binding to a SIRT enzyme, with each “turn” of the enzymatic cycle, manipulates DNA expression in a way that adds time to one’s life!
NAD+ levels decline with aging and represent a fundamental, systemic cause of aging.5 Falling NAD+ levels mean fewer “coins” in the “parking meter” represented by SIRT enzymes, which in turn means reduced life span, as age-accelerating genes are expressed without regulation.
Nicotinamide riboside has been scientifically proven to maintain robust levels of NAD+ in cells, thereby both supporting vital cellular energy functions and activating the anti-aging enzymes SIRT1 and SIRT3.43,63 Research has demonstrated that nicotinamide riboside supplementation is capable of reversing many of the age-accelerating changes induced by falling NAD+ levels.43 This is why the discovery nicotinamide riboside is so essential for any serious longevity regimen.
References
- Busso N, Karababa M, Nobile M, et al. Pharmacological inhibition of nicotinamide phosphoribosyltransferase/visfatin enzymatic activity identifies a new inflammatory pathway linked to NAD. PLoS One. 2008 May 21;3(5):e2267.
- Sauve AA. NAD+ and vitamin B3: from metabolism to therapies. J Pharmacol Exp Ther. 2008 Mar;324(3):883-93.
- Belenky P, Racette FG, Bogan KL, McClure JM, Smith JS, Brenner C. Nicotinamide riboside promotes Sir2 silencing and extends lifespan via Nrk and Urh1/Pnp1/Meu1 pathways to NAD+. Cell. 2007 May 4;129(3):473-84.
- Imai S, Armstrong CM, Kaeberlein M, Guarente L. Transcriptional silencing and longevity protein Sir2 is an NAD-dependent histone deacetylase. Nature. 2000 Feb 17;403(6771):795-800.
- Gomes AP, Price NL, Ling AJ, et al. Declining NAD(+) induces a pseudohypoxic state disrupting nuclear-mitochondrial communication during aging. Cell. 2013 Dec 19;155(7):1624-38.
- Available at: http://investors.chromadex.com/phoenix.zhtml?c=212121&p=irol-newsarticle&id=1936672&highlight=. Accessed August 29, 2014.
- Satoh MS, Poirier GG, Lindahl T. NAD(+)-dependent repair of damaged DNA by human cell extracts. J Biol Chem. 1993 Mar 15;268(8):5480-7.
- Anderson RM, Bitterman KJ, Wood JG, et al. Manipulation of a nuclear NAD+ salvage pathway delays aging without altering steady-state NAD+ levels. J Biol Chem. 2002 May 24;277(21):18881-90.
- Gong B, Pan Y, Vempati P, et al. Nicotinamide riboside restores cognition through an upregulation of proliferator-activated receptor-gamma coactivator 1alpha regulated beta-secretase 1 degradation and mitochondrial gene expression in Alzheimer’s mouse models. Neurobiol Aging. 2013 Jun;34(6):1581-8.
- Imai SI, Guarente L. NAD and sirtuins in aging and disease. Trends Cell Biol. 2014 Aug;24(8):464-71.
- Prolla TA, Denu JM. NAD+ deficiency in age-related mitochondrial dysfunction. Cell Metab. 2014 Feb 4;19(2):178-80.
- Villalba JM, Alcaín FJ. Sirtuin activators and inhibitors. Biofactors. 2012 Sep-Oct;38(5):349-59.
- Landry J, Sutton A, Tafrov ST, et al. The silencing protein SIR2 and its homologs are NAD-dependent protein deacetylases. Proc Natl Acad Sci USA. 2000 May 23;97(11):5807-11.
- Price NL, Gomes AP, Ling AJ, et al. SIRT1 is required for AMPK activation and the beneficial effects of resveratrol on mitochondrial function. Cell Metab. 2012 May 2;15(5):675-90.
- Higashida K, Kim SH, Jung SR, Asaka M, Holloszy JO, Han DH. Effects of resveratrol and SIRT1 on PGC-1α activity and mitochondrial biogenesis: a reevaluation. PLoS Biol. 2013 Jul;11(7):e1001603.
- Canto C, Auwerx J. Targeting sirtuin 1 to improve metabolism: all you need is NAD(+)? Pharmacol Rev. 2012 Jan;64(1):166-87.
- Hirschey MD, Shimazu T, Huang JY, Schwer B, Verdin E. SIRT3 regulates mitochondrial protein acetylation and intermediary metabolism. Cold Spring Harb Symp Quant Biol. 2011;76:267-77.
- Chen Y, Fu LL, Wen X, et al. Sirtuin-3 (SIRT3), a therapeutic target with oncogenic and tumor-suppressive function in cancer. Cell Death Dis. 2014 Feb 6;5:e1047.
- Scher MB, Vaquero A, Reinberg D. SirT3 is a nuclear NAD+-dependent histone deacetylase that translocates to the mitochondria upon cellular stress. Genes Dev. 2007 Apr 15;21(8):920-8.
- Kotas ME, Gorecki MC, Gillum MP. Sirtuin-1 is a nutrient-dependent modulator of inflammation. Adipocyte. 2013 Apr 1;2(2):113-8.
- Gallí M, Van Gool F, Leo O. Sirtuins and inflammation: Friends or foes? Biochem Pharmacol. 2011 Mar 1;81(5):569-76.
- Li X, Kazgan N. Mammalian sirtuins and energy metabolism. Int J Biol Sci. 2011 Feb; 7(5):575-87.
- Chang HC, Guarente L. SIRT1 and other sirtuins in metabolism. Trends Endocrinol Metab. 2014 Mar;25(3):138-45.
- Lu SP, Kato M, Lin SJ. Assimilation of endogenous nicotinamide riboside is essential for calorie restriction-mediated life span extension in Saccharomyces cerevisiae. J Biol Chem. 2009 Jun 19;284(25):17110-9.
- Morris KC, Lin HW, Thompson JW, Perez-Pinzon MA. Pathways for ischemic cytoprotection: role of sirtuins in caloric restriction, resveratrol, and ischemic preconditioning. J Cereb Blood Flow Metab. 2011 Apr;31(4):1003-19.
- Morselli E, Maiuri MC, Markaki M, et al. Caloric restriction and resveratrol promote longevity through the Sirtuin-1-dependent induction of autophagy. Cell Death Dis. 2010;1:e10.
- Sebastián C , Satterstrom FK,Haigis MC, Mostoslavsky R. From sirtuin biology to human diseases: an update. J Biol Chem. 2012 Dec 14;287(51):42444-52.
- Min SW, Sohn PD, Cho SH, Swanson RA, Gan L. Sirtuins in neurodegenerative diseases: an update on potential mechanisms. Front Aging Neurosci. 2013 Sep 25;5:53.
- Oellerich MF, Potente M. FOXOs and sirtuins in vascular growth, maintenance, and aging. Circ Res. 2012 Apr 27;110(9):1238-51.
- Haigis MC, Sinclair DA. Mammalian sirtuins: biological insights and disease relevance. Annu Rev Pathol. 2010;5:253-95.
- Kemper JK, Choi SE, Kim DH. Sirtuin 1 deacetylase: a key regulator of hepatic lipid metabolism. Vitam Horm. 2013;91:385-404.
- Tao R, Wei D, Gao H, Liu Y, DePinho RA, Dong XC. Hepatic FoxOs regulate lipid metabolism via modulation of expression of the nicotinamide phosphoribosyltransferase gene. J Biol Chem. 2011 Apr 22;286(16):14681-90.
- Schug TT, Li X. Sirtuin 1 in lipid metabolism and obesity. Ann Med. 2011 May;43(3):198-211.
- Ahn J, Lee H, Jung CH, Jeon TI, Ha TY. MicroRNA-146b promotes adipogenesis by suppressing the SIRT1-FOXO1 cascade. EMBO Mol Med. 2013 Oct;5(10):1602-12.
- Pang W, Wang Y, Wei N, et al. Sirt1 inhibits akt2-mediated porcine adipogenesis potentially by direct protein-protein interaction. PLoS One. 2013;8(8):e71576.
- Frojdo S, Durand C, Molin L, et al. Phosphoinositide 3-kinase as a novel functional target for the regulation of the insulin signaling pathway by SIRT1. Mol Cell Endocrinol. 2011 Mar 30;335(2):166-76.
- Sasaki T, Kim HJ, Kobayashi M, et al. Induction of hypothalamic Sirt1 leads to cessation of feeding via agouti-related peptide. Endocrinology. 2010 Jun;151(6):2556-66.
- Feige JN, Lagouge M, Canto C, et al. Specific SIRT1 activation mimics low energy levels and protects against diet-induced metabolic disorders by enhancing fat oxidation. Cell Metab. 2008 Nov;8(5):347-58.
- Green MF, Hirschey MD. SIRT3 weighs heavily in the metabolic balance: a new role for SIRT3 in metabolic syndrome. J Gerontol A Biol Sci Med Sci. 2013 Feb;68(2):105-7.
- Khan NA, Auranen M, Paetau I, et al. Effective treatment of mitochondrial myopathy by nicotinamide riboside, a vitamin B3. EMBO Mol Med. 2014 Apr 6;6(6):721-31.
- Belenky P, Stebbins R, Bogan KL, Evans CR, Brenner C. Nrt1 and Tna1-independent export of NAD+ precursor vitamins promotes NAD+ homeostasis and allows engineering of vitamin production. PLoS One. 2011 May 11;6(5):e19710.
- Kirkland JB . Niacin requirements for genomic stability. Mutat Res. 2012 May 1;733(1-2):14-20.
- Canto C, Houtkooper RH, Pirinen E, et al. The NAD(+) precursor nicotinamide riboside enhances oxidative metabolism and protects against high-fat diet-induced obesity. Cell Metab. 2012 Jun 6;15(6):838-47.
- Belenky PA, Moga TG, Brenner C. Saccharomyces cerevisiae YOR071C encodes the high affinity nicotinamide riboside transporter Nrt1. J Biol Chem. 2008 Mar 28;283(13):8075-9.
- Waterhouse NJ. The cellular energy crisis: mitochondria and cell death. Med Sci Sports Exerc. 2003 Jan;35(1):105-10.
- Palmeira CM, Rolo AP. Mitochondrial membrane potential (ΔΨ) fluctuations associated with the metabolic states of mitochondria. Methods Mol Biol. 2012;810:89-101.
- Smith CP, Thorsness PE. The molecular basis for relative physiological functionality of the ADP/ATP carrier isoforms in Saccharomyces cerevisiae. Genetics. 2008 Jul;179(3):1285-99.
- Mouchiroud L, Houtkooper RH, Moullan, et al. The NAD(+)/Sirtuin pathway modulates longevity through activation of mitochondrial UPR and FOXO signaling. Cell . 2013 Jul 18;154(2):430-41.
- Bogan KL, Evans C, Belenky P, et al. Identification of Isn1 and Sdt1 as glucose- and vitamin-regulated nicotinamide mononucleotide and nicotinic acid mononucleotide [corrected] 5’-nucleotidases responsible for production of nicotinamide riboside and nicotinic acid riboside. J Biol Chem. 2009 Dec 11;284(50):34861-9.
- Tosato M, Zamboni V, Ferrini A, Cesari M. The aging process and potential interventions to extend life expectancy. Clin Interv Aging. 2007;2(3):401-12.
- Larson EB, Yaffe K, Langa KM. New insights into the dementia epidemic. N Engl J Med. 2013 Dec 12;369(24):2275-7.
- Brookmeyer R, Johnson E, Ziegler-Graham K, Arrighi HM. Forecasting the global burden of Alzheimer’s disease. Alzheimers Dement. 2007 Jul;3(3):186-91.
- Sasaki Y, Araki T, Milbrandt J. Stimulation of nicotinamide adenine dinucleotide biosynthetic pathways delays axonal degeneration after axotomy. J Neurosci. 2006 Aug 16;26(33):8484-91.
- Tempel W, Rabeh WM, Bogan KL, et al. Nicotinamide riboside kinase structures reveal new pathways to NAD+. PLoS Biol. 2007 Oct 2;5(10):e263.
- Wolfe GI, Baker NS, Amato A, et al. Chronic cryptogenic sensory polyneuropathy: clinical and laboratory characteristics. Arch Neurol. 1999 May;56(5):540-7.
- Van Asseldonk JT, Van den Berg LH, Kalmijn S, et al. Axon loss is an important determinant of weakness in multifocal motor neuropathy. J Neurol Neurosurg Psychiatry. 2006 Jun;77(6):743-7.
- Hanada T, Weitzer S, Mair B, et al. CLP1 links tRNA metabolism to progressive motor-neuron loss. Nature. 2013 Mar 28;495(7442):474-80.
- Yang T, Chan NY, Sauve AA. Syntheses of nicotinamide riboside and derivatives: effective agents for increasing nicotinamide adenine dinucleotide concentrations in mammalian cells. J Med Chem. 2007 Dec 27;50(26):6458-61.
- North BJ, Verdin E. Sirtuins: Sir2-related NAD-dependent protein deacetylases. Genome Biol. 2004;5(5):224.
- Feige JN, Auwerx J. Transcriptional targets of sirtuins in the coordination of mammalian physiology. Curr Opin Cell Biol. 2008 Jun;20(3):303-9.
- Jin L, Wei W, Jiang Y, et al. Crystal structures of human SIRT3 displaying substrate-induced conformational changes. J Biol Chem. 2009 Sep 4;284(36):24394-405.
- Hirschey MD, Shimazu T, Capra JA, Pollard KS, Verdin E. SIRT1 and SIRT3 deacetylate homologous substrates: AceCS1,2 and HMGCS1,2. Aging (Albany NY). 2011 Jun;3(6):635-42.
- Belenky P, Christensen KC, Gazzaniga F, Pletnev AA, Brenner C. Nicotinamide riboside and nicotinic acid riboside salvage in fungi and mammals. Quantitative basis for Urh1 and purine nucleoside phosphorylase function in NAD+ metabolism. J Biol Chem. 2009 Jan 2;284(1):158-64.
- Mouchiroud L, Molin L, Kasturi P, et al. Pyruvate imbalance mediates metabolic reprogramming and mimics lifespan extension by dietary restriction in Caenorhabditis elegans. Aging Cell. 2011 Feb;10(1):39-54.